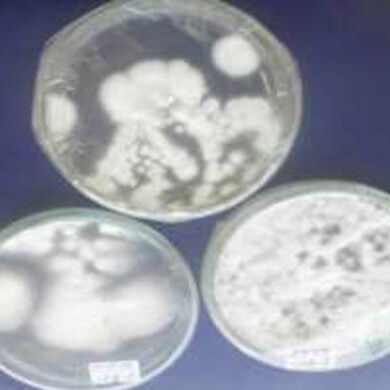

Mohammed. Elbashir
- بحوث منفردة

Establishment and detection of some Sudanease isolates of Beauveria bassiana (Balsamo) Vuillemin in Mejdhool seedling variety of date palm Phoenix dactylifera as prerequsit for prophyletic protection against pests and diseases
Endophytic fungi, which live within host plant tissues asymp
أكمل القراءة »